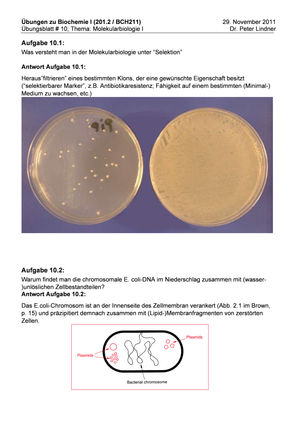

Damit du dich schnell zurecht findest, möchten wir dir in kurzen Schritten und weniger als 5 Minuten einen Überblick über die wichtigsten und relevantesten Neuerungen geben.
Next: Gemeinsam studieren – wie du dich in die Community einbringen kannst
Tour starten
Eine Community lebt vom gemeinsamen Austausch. Geh mit gutem Beispiel voran und bewerte deine Kurse, teile deine Dateien,
stelle und beantworte Fragen, verkaufe deine alten Bücher, schriebe Wohnraum aus oder teile Events.
Next: Alles auf einen Klick – die neue Toolleiste
Weiter
Du findest neu auf der linken Seite ein Navigationsmenu, mit dem du dich nicht nur schnell und einfach durch alle
Tools durchklicken kannst, sondern auch direkt auf deine abonnierten Kurse zugreifen kannst.
Next: Deine Communitybeiträge
Weiter

Die wichtigste Änderung ist, dass du dich von nun an nicht mehr mühsam durch alle Tools klicken musst, um an die relevanten Inhalte zu gelangen,
sondern dass deine Kurse (Vorlesungen, Module, Übungen…) und alle dazugehörigen Inhalte im Zentrum stehen. Über deine Profil-Einstellungen,
das heisst das Zahnrad oben rechts und dann den Link „Meine Kurse“ gelangst du zur Kurswahl.
Next: Dein virtualer Hörsaal – die neuen Kursseiten
Weiter
Alles, was es zu deinen abonnierten Kursen zu wissen und erfahren gibt, findest du auf den neuen Kursseiten:
Zum jeweiligen Kurs passende und neue Beiträge aus dem Forum, geteilte Dateien (Zusammenfassungen, alter Prüfungen, etc.)
aus dem FileExchange, Erfahrungsberichte aus den Kursbewertungen sowie zu (ver)kaufende Bücher aus dem Marktplatz.
Next: Deine Communitybeiträge
Weiter

Alles was du für die Community bereitstellst, wird in deinem Profil abgelegt. Von hier kannst du auf die Inhalte zugreifen und Anpassungen vornehmen.
Next: Die Startseite ist dein Dashboard
Weiter
Lerne Arbeitgeber kennen, finde Jobs und Karrierechancen, erfahre von Events, profitiere von Rabatten und Tipps, oder suche nach Wohnungen und WG-Gspänli. Klick dich durch, es lohnt sich!
Weiter
Jetzt wünschen wir dir viel Spass mit dem neuen uniboard.ch. Wir haben zwar die letzten Jahre fieberhaft daran gearbeitet, falls dir aber noch etwas auffällt,
was besser sein könnte oder du Ideen für neue Tools und Funktionen hast, melde dich gerne jederzeit bei uns!
Tour beenden